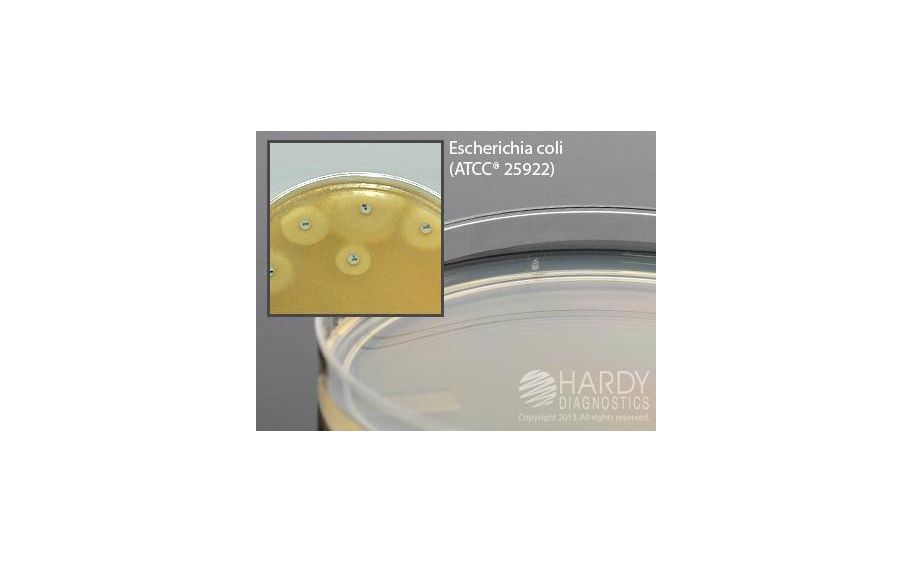
main product photo

Need Help?
800-229-7252

MUELLER HINTON AGAR 15X100MM PLATE PK10
1
/
PK
Lead Time
12 Day(s)
SKU
VWR10054-352-PK
MFRPN
G45
MUELLER HINTON AGAR 15X100MM PLATE PK10
Mueller Hinton Agar For disk susceptibility testing, 28ml fill, 15x100mm plate, order by the package of 10, This is the smaller Mueller Hinton plate that will hold up to five antimicrobial disks. Polystyrene Petri plates feature raised rings for stacking ability and prevents sliding.
| Manufacturer | Hardy Diagnostics |
|---|---|
| MFRPN | G45 |
| Lead Time | 12 Day(s) |
| UNSPSC Code | 12000000 |
Write Your Own Review